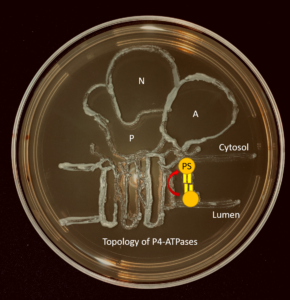
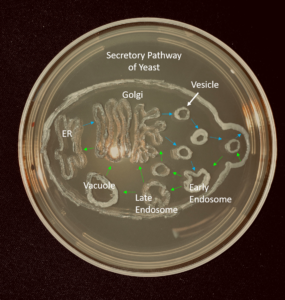
MicrosoftTeams-image (1)

The overall goal of our lab is to determine how biological membranes are assembled and organized. This includes analysis of how proteins are localized to the appropriate organelles in the secretory and endocytic pathways, and how P4-ATPases contribute to membrane asymmetry, protein trafficking, and human disease. Our research relies heavily on the use of model systems, such as Saccharomyces cerevisiae and mus musculus, and techniques such as molecular cloning, cell imaging, flow cytometry, genetics, and biochemical analysis of proteins. Read more.